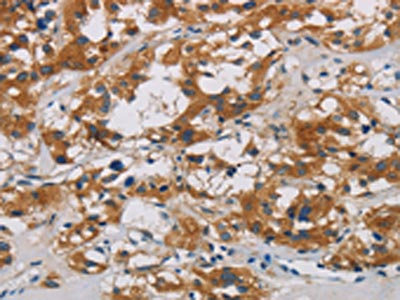

CNDP1 Antibody
-
中文名稱:CNDP1兔多克隆抗體
-
貨號:CSB-PA439589
-
規格:¥1100
-
圖片:
-
The image is immunohistochemistry of paraffin-embedded Human gastic cancer tissue using CSB-PA439589(CNDP1 Antibody) at dilution 1/30. (Original magnification: ×200)
-
The image is immunohistochemistry of paraffin-embedded Human thyroid cancer tissue using CSB-PA439589(CNDP1 Antibody) at dilution 1/30. (Original magnification: ×200)
-
Gel: 8%SDS-PAGE, Lysate: 40 μg, Lane: 293T cells, Primary antibody: CSB-PA439589(CNDP1 Antibody) at dilution 1/320, Secondary antibody: Goat anti rabbit IgG at 1/8000 dilution, Exposure time: 10 seconds
-
-
其他:
產品詳情
-
Uniprot No.:
-
基因名:CNDP1
-
別名:Beta Ala His dipeptidase antibody; Beta-Ala-His dipeptidase antibody; Carnosinase 1 antibody; Carnosinase1 antibody; Carnosine dipeptidase 1 (metallopeptidase M20 family) antibody; Carnosine dipeptidase 1 antibody; CN1 antibody; CNDP 1 antibody; CNDP dipeptidase 1 antibody; Cndp1 antibody; CNDP1_HUMAN antibody; CPGL2 antibody; Glutamate carboxypeptidase like protein 2 antibody; Glutamate carboxypeptidase-like protein 2 antibody; HsT2308 antibody; MGC102737 antibody; MGC10825 antibody; MGC142072 antibody; OTTHUMP00000163751 antibody; Serum carnosinase antibody; UNQ1915/PRO4380 antibody
-
宿主:Rabbit
-
反應種屬:Human,Mouse,Rat
-
免疫原:Fusion protein of Human CNDP1
-
免疫原種屬:Homo sapiens (Human)
-
標記方式:Non-conjugated
-
抗體亞型:IgG
-
純化方式:Antigen affinity purification
-
濃度:It differs from different batches. Please contact us to confirm it.
-
保存緩沖液:-20°C, pH7.4 PBS, 0.05% NaN3, 40% Glycerol
-
產品提供形式:Liquid
-
應用范圍:ELISA,WB,IHC
-
推薦稀釋比:
Application Recommended Dilution ELISA 1:2000-1:5000 WB 1:500-1:2000 IHC 1:50-1:200 -
Protocols:
-
儲存條件:Upon receipt, store at -20°C or -80°C. Avoid repeated freeze.
-
貨期:Basically, we can dispatch the products out in 1-3 working days after receiving your orders. Delivery time maybe differs from different purchasing way or location, please kindly consult your local distributors for specific delivery time.
-
用途:For Research Use Only. Not for use in diagnostic or therapeutic procedures.
相關產品
靶點詳情
-
功能:Catalyzes the peptide bond hydrolysis in Xaa-His dipeptides, displaying the highest activity toward carnosine (beta-alanyl-L-histidine) and anserine (beta-alanyl-3-methyl-histidine).
-
基因功能參考文獻:
- The distribution of the (CTG)5 homozygous genotype in the no-diabetic nephropathy (DN) and clinical-DN patients was comparable, a lower frequency was found in the biopsy proven-DN patients, particularly in females. We observed a significant trend towards high frequencies of the (CTG)5 homozygous genotype with increased time on dialysis. PMID: 28553654
- Considering that approximately 40 per cent of the population are homozygous for the 5L allele of (CTG) n repeat polymorphism in CNDP1 gene and seem to be less prone to develop DN, it is needed to evaluate whether the majority of diabetic patients (who do not have the 5L-5L genotype) would be benefited from supplementation with carnosine or with a more intensive monitoring PMID: 27834319
- Compared to healthy individuals and those with diabetes but no kidney disease, patients with diabetic nephropathy exhibited lower frequencies of 5L-5L genotype and 5L allele of CNDP1 gene, suggesting that this allele might confer protection against development of kidney disease in this population. PMID: 27834323
- genetic association studies in pediatric population in Germany: Data suggest that, in pediatric patients with chronic kidney disease, the nephroprotective effect of CNDP1 Mannheim genetic variant against disease progression is not restricted to patients with diabetic nephropathy. PMID: 27278783
- The experimentally measured higher affinity of homocarnosine for the enzyme relative to l-carnosine might be explained, at least in part, by more extensive interactions inside the monomeric and dimeric hCN1's active site. PMID: 27105448
- Data shows that higher carnosine content in human skeletal muscle is positively associated with insulin resistance and fasting metabolic preference for glucose. PMID: 26439389
- In gastrointestinal cancer, reduced plasma levels of CNDP1 associate with signs of catabolism and poor outcome. PMID: 25898255
- Alterations of serum carnosinase (CN1) activity has been associated with several pathological conditions, such as neurological disorders, chronic diseases and cancer PMID: 24566305
- This meta-analysis confirms that the carnosinase D18S880 microsatellite polymorphism is associated with daibetic nephropathy susceptibility, especially in the type 2 DM and the Caucasian population. PMID: 23402577
- Rs12604675-A in CNDP1 may confer susceptibility to overt proteinuria in Japanese women with type 2 diabetes. PMID: 23342076
- In this review, correlations between serum carnosine and carnosinase activity and polymorphism in CNDP1 gene are analyzed. The role of CNDP1 gene polymorphism the development of diabetic nephropathy and non-diabetic chronic kidney disease is discussed. PMID: 22706107
- Plasma levels of FLT and S100A9 proteins are up-regulated and CNDP1 levels are down-regulated in patients with glioblastoma. PMID: 23029420
- These findings provide nominal evidence supporting a role between CNDP1 variants and diabetic kidney disease. PMID: 21393041
- neither CNDP1 genotype nor the normal variation in circulating testosterone levels affects the muscular carnosine content PMID: 20865290
- Serum histidine dipeptide concentrations are not correlated to serum carnosinase activity PMID: 20971102
- CNDP1 polymorphism predicts progression to ESRD in patients with diabetic nephropathies, but only late after baseline measurements. PMID: 20711718
- CTG polymorphism of the CNDP1 gene does not affect survival of Chinese peritoneal dialysis subjects. PMID: 20979941
- Hyperglycemia enhances CNDP1 secretion and enzyme activity; data suggest that poor blood glucose control in diabetic patients might result in an increased enzyme secretion even in the presence of the (CTG)(5) allele. PMID: 20460427
- Association between the CNDP1 gene and diabetic nephropathy is sex specific and independent of susceptibility for type 2 diabetes. PMID: 20332346
- GCP II mRNA was detected in glial cells. Glial-rich regions, specifically the DLPFC and ERC white matter and the molecular and polymorphic layers in the hippocampus, express high levels of GCP II mRNA. PMID: 14560319
- diabetic patients with the carnosinase CNDP1 gene Mannheim variant are less susceptible for nephropathy PMID: 16046297
- no difference in allele or genotype frequency between centenarians & controls or between cardiovascular patients & controls; the recently identified functional carnosinase variant does not contribute to longevity or protect against coronary heart disease PMID: 16965804
- CPGL-B may be associated with cell growth and metastasis of HCC. PMID: 17121880
- This replicates the CNDP1 gene association with diabetic nephropathy (DN) that was initially detected in European Caucasians and in Arabs, and further demonstrates that the CNDP1 gene and carnosine pathway appear to play a role in susceptibility to DN. PMID: 17205963
- Diabetic patients homozygous for CNDP1 are protected against diabetic nephropathy. PMID: 17601991
- CN1-dependent susceptibility to diabetic nephropathy may at least in part be mediated by altered glucose metabolism in type 2 diabetic patients. PMID: 17601992
- South Asian Surinamese have a lower frequency of the 5/5 homozygous genotype, which was associated with lower carnosinase activity and genetic risk for developing diabetic nephropathy. PMID: 19577318
顯示更多
收起更多
-
亞細胞定位:Secreted.
-
蛋白家族:Peptidase M20A family
-
組織特異性:Found in serum and adult nervous central system. Absent in serum from patients with homocarnosinosis.
-
數據庫鏈接:
Most popular with customers
-
-
YWHAB Recombinant Monoclonal Antibody
Applications: ELISA, WB, IHC, IF, FC
Species Reactivity: Human, Mouse, Rat
-
Phospho-YAP1 (S127) Recombinant Monoclonal Antibody
Applications: ELISA, WB, IHC
Species Reactivity: Human
-
-
-
-
-